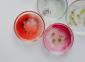

Jong Talent Pfizer Prijzen voor Life Sciences 2022
Drie jonge veelbelovende onderzoekers kregen pas geleden de Jong Talent Pfizer Prijzen voor Life Sciences 2022 uitgereikt door Marc Kaptein, medisch directeur bij Pfizer. De eerste prijs werd gewonnen door Laurens Spoelstra, die zich tijdens zijn afstudeerproject heeft vastgebeten in onderzoek naar een kniegewricht op een computerchip. ’’Je kunt daarmee op kleine schaal, gericht en met veel controle nabootsen wat er in het menselijk lichaam gebeurt bij artrose’’

Inmiddels doet Laurens promotieonderzoek bij het lab waar hij ook zijn afstudeerproject voor zijn studie Biomedical Engineering aan de Universiteit Twente deed. ’’Artrose is een maatschappelijk relevant probleem. Op moleculair niveau zit artrose ingewikkeld in elkaar. Maar ik hou van puzzelen’’, vertelde Laurens na afloop van de prijsuitreiking waar hij een cheque van 3000 euro in ontvangst nam.
Jury
Laurens scriptie was een van de vele afstudeerscripties waar de jury van de Jong Talent Pfizer Prijzen voor Life Sciences 2022 zich dit najaar over boog. De jury bestond dit keer uit prof. dr. Inez de Beaufort, emeritus-hoogleraar gezondheidsethiek van de Erasmus Universiteit, prof. dr. Mihai Netea, hoogleraar experimentele interne geneeskunde van het Radboud UMC en prof dr. Roos Masereeuw, hoogleraar experimentele farmacologie van de Universiteit Utrecht en wetenschappelijk directeur van het Utrecht Institute for Pharmaceutical Sciences.
Zij hadden een flinke dobber aan het beoordelen van alle scripties, waarvan er vele van zeer hoge wetenschappelijke kwaliteit waren. Toch stak de scriptie van Laurens Spoelstra, die ‘biomedical engineering’ aan de Universiteit Twente studeerde, er met kop en schouders bovenuit.
Volgens de jury heeft het kniegewricht op een chip dat Laurens en zijn collega’s willen ontwikkelen ‘de potentie om ermee nieuwe behandelingen te ontwikkelen voor de behandeling van de 1,5 miljoen Nederlanders met artrose’.

Daarmee is zijn onderzoek bijzonder maatschappelijk relevant. Bovendien kan het gebruik van organen op chips er in de toekomst toe leiden dat er veel minder proefdierenonderzoek nodig is. De jury noemt het onderzoekswerk dat Laurens de komende jaren voortzet ‘veelbelovend’ en vindt Laurens dan ook ‘de terechte winnaar van de Jong Talent Pfizer Prijzen voor Life Sciences 2022’.
Onderzoek naar nieuwe antibiotica
Maar ook over de winnaar van de tweede prijs, Jeroen Punt, die ‘Life Science & Technology’ studeerde aan de TU Delft & Leiden Universiteit en onderzoek deed naar de ontwikkeling van nieuwe antibiotica, is de jury vol lof.
Met collega’s onderzocht Jeroen of de circa 3000 stoffen uit de database van onderzoeksgroep ‘molecular psyhiology’ potentieel bacteriedodend zijn.

Vervolgens ging hij aan de slag met een veelbelovend stofje ‘Lei-800’. Hij paste dit stofje aan en bestudeerde welk enzym er nou precies voor zorgt dat ‘Lei-800’ gramnegatieve bacteriën doodt. Collega-onderzoekers doen nu vervolgonderzoek naar dat betreffende enzym, ‘DNA gyrase’. Ook onderzoeken ze of Lei-800 kan worden doorontwikkeld tot een nieuw antibioticum.
‘Zeldzaam dat het werk van een jonge onderzoeker zo maatschappelijk relevant is’
Het is volgens de jury ‘zeldzaam’ dat het werk van een jonge onderzoeker zo maatschappelijk relevant en tegelijkertijd biologisch enorm spannend is. ‘We twijfelen er niet aan dat deze prijs een verdere aanmoediging betekent voor een succesvolle wetenschappelijke carrière’, stelt de jury.
Tot slot heeft Elena Camerini, die ‘Molecular Life Sciences’ studeerde aan de Radboud Universiteit, volgens de jury ‘een welverdiende derde plek behaald.’

Zij heeft volgens de jury waardevol onderzoek gedaan naar de mogelijkheid om immunotherapie bij leukemie ook succesvol in te zetten bij mensen met hersentumoren.
De jury zegt ‘onder de indruk te zijn van Elena’s enthousiasme en haar toewijding aan haar onderzoek’. En schrijft in haar rapport: ‘We hopen dat zulk onderzoek bijdraagt aan ontwikkelingen waarmee in de toekomst levens gered kunnen worden.
Op de website van de Koninklijke Hollandsche Maatschappij der Wetenschappen kun je de juryrapporten bekijken.